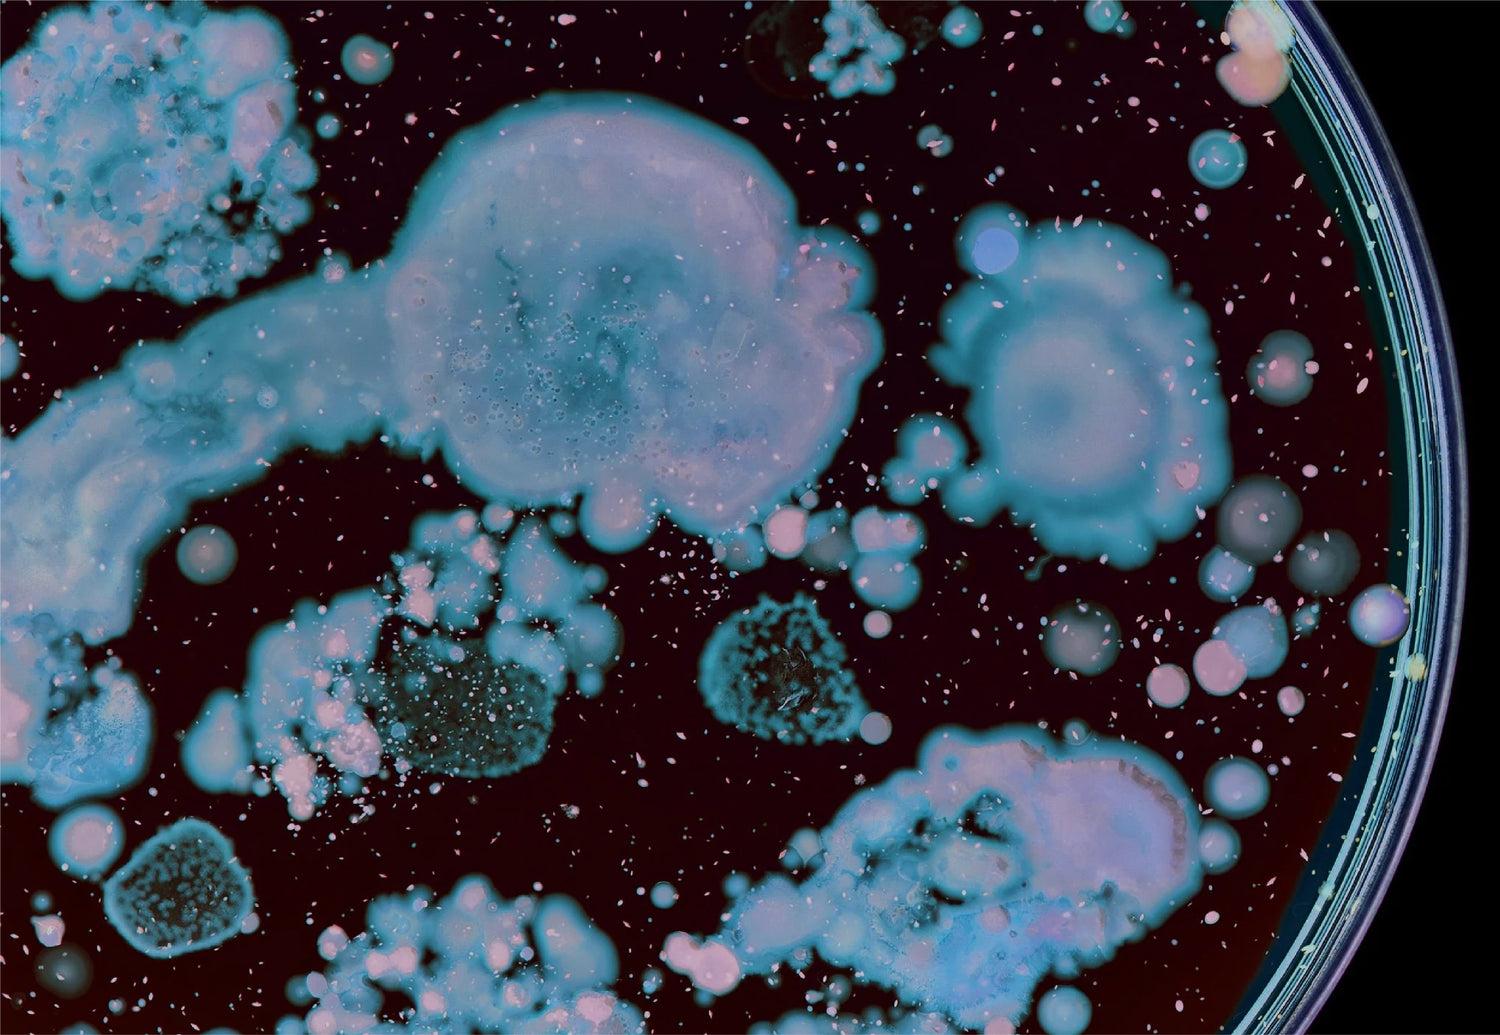

INNOVATIVE FORMULAS
OUR INGREDIENTS
From plants to natural compounds and minerals, we are finding ingredients with the sole purpose to better your skin.

A NATURAL GAME CHANGER
Exclusive to Lira Clinical, MASQ TECH™ is derived from the Pistacia Lentiscus tree, native to Chios, Greece, a region known for its rich volcanic soil and potent microclimate. These conditions create an exceptionally active form of Mastiha extract, which Lira Clinical uses in four different forms throughout their formulations:
- Oil – The most potent form, rich in actives
- Extract
- Freeze-dried powder
- Granules
Key benefits of Mastiha: antimicrobial, anti-inflammatory, retinol-like renewal, and advanced skin repair and healing.

DELIVERING IMPRESSIVE RESULTS
A scientific breakthrough in ingredient delivery, EXO-TECH™ enhances performance while protecting the skin’s delicate barrier. This advanced delivery system allows active ingredients to penetrate deeply into the epidermis without irritation or compromise to barrier function.
By enabling precise, targeted delivery, EXO-TECH™ ensures that each formula works at the source of skin concerns, optimizing results and supporting healthier, more resilient skin.

THE POWER OF RETINOL
Lira Clinical harnesses the restorative powers of four types of retinoids across its treatment and home care lines. These active forms of vitamin A work to strengthen the epidermis, encouraging a healthy cell turnover and stimulating the production of collagen and elastin. Therefore, our use of retinoids is beneficial to many skin types and concerns. Find out more
about our innovative use of retinol by visiting ‘The Power of Retinol’ page and discover which of our retinol-rich products is best for your skin.
Retinol – The power to regulate and repair.

NATURALLY THE BEST
Lira Clinical harnesses the power of 12 advanced plant stem cells to repair, protect, and rejuvenate the skin. Each stem cell is carefully selected for its unique regenerative properties, helping to strengthen the skin’s barrier, stimulate collagen and elastin, and restore balance to stressed or damaged skin.
These botanical actives target specific skin concerns:
Alpine Rose strengthens the barrier, Edelweiss boosts collagen, Lilac calms acne and brightens, Madonna Lily and Sea Fennel reduce pigmentation, Swiss Apple promotes healing, Orange enhances elasticity, Echinacea supports recovery, Argan repairs, Grape protects from UV damage, Papyrus deeply hydrates, and Butterfly Bush improves skin immunity.
Together, this intelligent stem cell complex supports healthier, more resilient, and visibly renewed skin.

VITAMIN C COMPLEX
A powerful antioxidant that supports collagen production, repairs oxidative damage, and enhances skin luminosity. Lira Clinical combines two types of Vitamin C (water- and oil-soluble) across four stabilized forms for maximum potency, minimal irritation, and lasting results.
- L-Ascorbic Acid – Water-soluble; renews skin cells, brightens dullness, and reduces pigmentation.
- Tetrahexyldecyl Ascorbate (THD Ascorbate / BV-OSC) – Oil-soluble and highly stable; increases collagen by up to 50% and smooths fine lines and wrinkles.
- Magnesium Ascorbyl Phosphate – A hydrating ester form that enhances skin moisture and stability.
- Sodium Ascorbyl Phosphate – A stabilized form with antimicrobial properties that reduce acne-causing bacteria and inflammation.

SMALL THINGS MAKE A BIG DIFFERENCE
Our clever use of colloidal minerals, such as colloidal gold and silver, ensures efficient and effective absorption deep into the skin for optimum skin-changing outcomes. The capabilities of many of our colloidal minerals to reduce bacteria and inflammation whilst supporting skin repair make them a vital ingredient in many of our products. These tiny particles, suspended within many of our formulations, offer multiple preventative and restorative benefits.

DESIGNER PEPTIDES
Peptides are cellular messengers that encourage collagen and elastin production, improving firmness and reducing expression lines. Lira Clinical’s Advanced Healing Peptide Delivery System enhances penetration while maintaining a healthy barrier.
Key peptides:
Matrixyl • Oligopeptide-68 • Palmitoyl Tripeptide • SNAP-8 • SYN-AKE

HYDRATION HERO
Renowned for its impressive skin hydration capabilities, our use of hyaluronic acid within our treatments and products results in improvements in skin suppleness and elasticity, as well as improving the skin’s ability to retain hydration. By boosting hydration levels and optimising moisture retention, skin texture is plumped, and skin tone looks radiant, making hyaluronic acid a game-changing ingredient in many of our formulations.
Hyaluronic Acid – A skin-quenching ingredient.
TOPICAL & CULTURED PROBIOTICS
Probiotics strengthen the skin’s microbiome, balancing beneficial bacteria and enhancing the skin’s immune response.
- Fermented Probiotics – Naturally derived from botanicals; enhance absorption and reduce surface irritation.
- Cultured Probiotics – Act like topical antibiotics, promoting a balanced microbiome for a resilient skin barrier.

EXFOLIATING ACIDS
Our use of water-soluble Alpha Hydroxy Acids (AHAs) including glycolic,mandelic and lactic acids work to exfoliate, refine and brighten the skin, all with their own niche specialisms. From the intense capabilities of glycolic acid to the softer approach of mandelic and lactic acids for more sensitive skin types, our use of AHAs within our products enables treatment programmes to be totally bespoke to the client’s goals, offering a progressive treatment pathways for optimum results.
AHA – Alpha Hydroxy Acids (Water-Soluble)
- Glycolic Acid – Refines texture, reduces lines, and brightens; the smallest AHA molecule for deep penetration.
- Mandelic Acid – Gentle exfoliation for sensitive skin, improving tone and clarity without irritation.
- Lactic Acid – Hydrating and brightening, suitable for all skin types.
BHA – Beta Hydroxy Acid (Oil-Soluble)
- Salicylic Acid (from Willow Bark) – Reduces inflammation, unclogs pores, and controls excess oil.

THE SKIN REFINING SPONGE
A natural freshwater sponge used as a physical exfoliant to stimulate microcirculation, oxygenate the skin, and refine texture. Found in Lira Clinical’s Green Power Smart Peel, Badiaga also firms and smooths, helping reduce fine lines and improve overall tone when blended with other formulations.

PLANT-POWERED SKIN SUPPORT
Naturally derived plant extracts that help repair, soothe, and strengthen the skin.
- Cut Leaf Ground Cherry – Calms heat and boosts immune defense.
- Gooseberry – High in Vitamin C; brightens and protects.
- Shiitake Mushroom – Rich in antioxidants; supports even tone, hydration, and barrier health.
- Silver Ear Mushroom – Deeply hydrating; holds five times more moisture than hyaluronic acid.

SKIN-NURTURING OILS
Our use of skin-nurturing oils, including coconut oil, boost and support skin health. Harnessing antimicrobial, antifungal and immune boosting properties as well as antioxidant ingredients, our use of oils helps to repair and restore skin tissues. Coconut oil is bursting with vitamin E and essential fatty acids, helping moisture retention to support smoother skin, minimise pores and refine overall skin texture.
Oils – A drop of pure indulgence
LIRA CLINICAL IS BRIGHTENING
Almost every product contains lightening agents and brightening botanicals to even skin tone
LIRA CLINICAL IS TRANSFORMATIVE
Skin health is restored with powerful anti-inflammatory agents, antioxidants and minerals.
LIRA CLINICAL IS ANTI-AGING
Younger looking skin is revealed with powerful peptides, plant stemcells and precise peel technology.